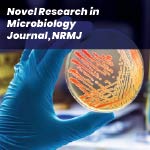

-
Call Us
-
E-mail Us
- International Conferences
Scopus Indexed Journals 2026
The present day academic landscape is highly competitive. In order to stay ahead of your fellow researchers, it is important to have some credible publications. In this constantly evolving field, researchers always try seeking avenues to share their groundbreaking work. And such avenues are none other than reputed journals. Among all, scopus indexed journals remain a cornerstone and benchmark of scholarly publication, offering global visibility and recognition. However, the sheer volume of options can be confusing and time consuming.
For those seeking a fast publishing Scopus journal, several factors have to be taken into consideration. Some journals try to showcase themselves as renowned ones by telling that they have a multilayered review processes, eligibility criteria etc. However it is crucial to carefully evaluate each journal's scope and credibility to ensure if it is a suitable fit for your work. The researchers also need to be careful with the rising cases of fake journals and targeted scams exploiting academicians. So it is better to give priority to Scopus Indexed Journals 2026 fast publication as it will be a trustable choice.
Cost considerations are equally important with regard to journal publications. Paid Scopus-indexed journals are chosen by few researchers who have a shorter timeline of completing their research work. While some journals may have substantial publication charges, many scopus indexed journals with low publication charges exist. Sometimes, Scopus-indexed journals allow free publications making them more accessible for researchers with limited budgets.
Ultimately, the key lies in finding a balance between speed, quality, and affordability. Thorough research and careful selection are very important to ensure your work reaches the right audience and contributes meaningfully to your field through Scopus Indexed Journals 2026.
Are you looking for suitable journals to publish in?

European Journal of Clinical and Experimental Medicine
ISSN : 2544-2406 / 2544-1361
Indexing : High Impact Indexing Database

Colombian Journal of Chemical-Pharmaceutical Sciences
E-SSN : 0034-7418
Indexing : High Impact Indexing Database

Environment and Ecology research
ISSN : 2331-625X (Print) 2331-6268 (Online)
Indexing : High Impact Indexing Database

International Journal of Pharmaceutical Research and Allied Sciences
ISSN : 2277-3657
Indexing : High Impact Indexing Database

Journal of Chemical Health Risks
ISSN : 2251-6719
Indexing : High Impact Indexing Database

Journal of Food and Raw materials
ISSN : 2308-4057
Indexing : High Impact Indexing Database

Journal of Medicinal and Chemical Sciences
ISSN : 2651-4702
Indexing : High Impact Indexing Database

Journal of International Dental and Medical Research
ISSN : 2651-4702
Indexing : High Impact Indexing Database

Journal of Pharmaceutical Research and Innovation (JPRI)
ISSN : 2583-0023
Indexing : High Impact Indexing Database
Novel Research in Microbiology Journal, NRMJ
ISSN :
Indexing : High Impact Indexing Database

Journal of Reports in Pharmaceutical Sciences
ISSN :2322-1232
Indexing : High Impact Indexing Database

Universal Journal of Public Health
ISSN :2331-8880 (Print)
Indexing : High Impact Indexing Database

Transaction on Biomedical Engineering Applications and Healthcare
ISSN :2582-7405 (Online)
Indexing : High Impact Indexing Database

Uttar Pradesh Journal of Zoology
ISSN :0256-971X
Indexing : High Impact Indexing Database

Advances in Pharmacology and Pharmacy
ISSN : 2332-0044
Indexing : ESCI (Web of Science), Google Scholar, Chemical Abstracts Service, EBSCO A-to-Z, Index Copernicus, J-Gate.

Advances in Pharmacology and Pharmacy
ISSN : 2332-0044
Indexing : ESCI (Web of Science), Google Scholar, Chemical Abstracts Service, EBSCO A-to-Z, Index Copernicus, J-Gate.

Russian Journal of Thoracic and Cardiovascular Surgery
ISSN : 0236-2791 (print) / 2410-8685 (online)
Indexing : High Impact Indexing Database

Creative Cardiology
ISSN : 1997-3187 (Print) / 2410-9169 (Online)
Indexing : High Impact Indexing Database

European Journal of Clinical and Experimental Medicine
ISSN : 2544-2406 / 2544-1361
Indexing : High Impact Indexing Database

Russian Journal of Thoracic and Cardiovascular Surgery
ISSN : 0236-2791 (print) / 2410-8685 (online)
Indexing : High Impact Indexing Database

Creative Cardiology
ISSN : 1997-3187 (Print) / 2410-9169 (Online)
Indexing : High Impact Indexing Database

European Journal of Clinical and Experimental Medicine
ISSN : 2544-2406 / 2544-1361
Indexing : High Impact Indexing Database

Russian Journal of Thoracic and Cardiovascular Surgery
ISSN : 0236-2791 (print) / 2410-8685 (online)
Indexing : High Impact Indexing Database

Creative Cardiology
ISSN : 1997-3187 (Print) / 2410-9169 (Online)
Indexing : High Impact Indexing Database
